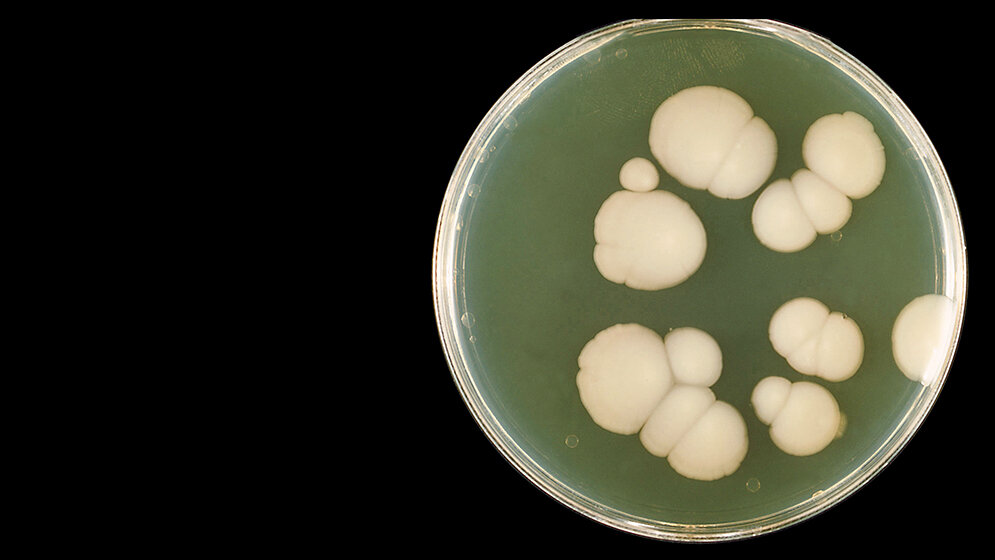
Die Rolle der Sprosspilze in der Medizin (Teil 1)

Die Rolle der Sprosspilze in der Medizin (Teil 1)
Zusammenfassung
Die Bezeichnung „Sprosspilz“ beruht auf dem morphologischen Merkmal der Knospung/Sprossung während der Vermehrung, obwohl diese Pilze auch gelegentlich in Filamentform vorkommen und umgekehrt viele filamentöse Pilze (die sogenannten Schimmelpilze) vorübergehend Sprosszellen ausbilden. Wie alle Pilze haben Sprosspilze einen zellulären Aufbau mit Zellkern, Zytoplasma und zytoplasmatischer Membran. Diese enthält anders als menschliche Zellen Ergosterin als wichtigsten Lipidbaustein und nicht Cholesterin. Im Gegensatz zur menschlichen Zelle besitzen Pilze aber eine starre Zellwand, die aus einem Geflecht von Polysacchariden (1–3ß-Glucan, 1–6ß-Glucan, Mannan) und Chitin besteht. In diese Grundstruktur sind noch Proteine, zum Teil Enzyme, eingebaut. Die Nomenklatur richtet sich einerseits nach der geschlechtlichen (teleomorphen) Erscheinung und andererseits nach der ungeschlechtlichen (anamorphen) Form, was im Labor Verwirrung stiftet, wenn ein Pilz zwei Namen trägt. In der Medizin ist der Name des Anamorph geläufig. Die grobe Einteilung der Pilze erfolgt nach den geschlechtlichen Erscheinungsformen, zum Beispiel in die Gruppe der Askomyzeten oder in die Gruppe der Basidiomyzeten. Zur Diagnostik werden morphologische Kriterien und die Kultur sowie die biochemische, massenspektroskopische und molekularbiologische Differenzierung herangezogen. Zur Therapie stehen nur ganz wenige Antimykotika aus der Gruppe der Polyene, der Azole und der Echinocandine zur Verfügung.
Schlüsselwörter: Sprosspilze, Ergosterin, teleomorph, anamorph
Abstract
The term „yeast“ stems from the morphologic character of budding during growth. On the other side yeasts may also form occasionally filaments and contrariwise most filamentous fungi (the so-called moulds) are able to produce budding cells. Like all fungi yeasts have a cellular structure with nucleus, cytoplasm and cytoplasmic membrane. The last one contains ergosterol instead of cholesterol as the principal lipid constituent. In contrast to the human cells yeasts possess a rigid cell wall consisting of a network of polysaccharides (1–3ß glucan, 1–6ß glucan, mannan) as well as chitin. In this basic structure several proteins, for example enzymes, are implanted. The nomenclature depends on one hand on the sexual (teleomorphic) and on the other hand on the asexual (anamorphic) form, which will create confusion in the lab, since 1 fungus will have 2 names. In medicine the name of the anamorph is used generally. The rough classification of fungi is done according to the sexual form, i.e. in the groups of ascomycetes or basidiomycetes. For diagnostic purposes morphologic criteria and culture are employed in addition with biochemical, massspectroscopic and molecular differentiation. For therapy only rather few antimycotics from the groups of polyenes, azoles and echinocandins are available.
Keywords: yeast, ergosterol, teleomorphic, anamorphic
DOI: 10.3238/MTADIALOG.2019.0864
Entnommen aus MTA Dialog 10/2019
Dann nutzen Sie jetzt unser Probe-Abonnement mit 3 Ausgaben zum Kennenlernpreis von € 19,90.
Jetzt Abonnent werden